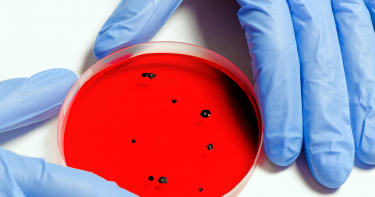
alt

變形蟲
」 食腦變形蟲 福氏內格里蟲 疾管署 親水設施 游泳
「食腦變形蟲」肆虐!印度爆致命腦膜腦炎疫情 死亡人數攀升至19人
印度的喀拉拉邦(Kerala)今年共造成 19 人死於極為罕見的寄生蟲感染「腦膜腦炎」(amoebic meningoencephalitis)。死者包括一名3個月大的嬰兒與一位52歲的成年人,其他則分布於不同年齡層。病源為「腦食蟲」,也就是「福氏內格里阿米巴原蟲」(Naegleria fowleri)引起。當局警告,病例數的快速攀升與感染模式的轉變,極可能與全球氣候變遷有關。根據《路透社》與《印度時報》報導,喀拉拉邦迄今已記錄超過 120 例此類腦膜腦炎病例,單今年就有 68 例。病毒經由受污染的淡水從鼻腔進入,攻擊腦部組織,當地有19人不幸死亡,日前在科日科德(Kozhikode)政府醫學院,一名嬰兒與一名婦女在接受治療期間不治。據了解,福氏內格里阿米巴原蟲通常透過鼻腔進入人體,然後迅速攻擊中樞神經系統,其全球致死率高達97%。喀拉拉邦衛生部長喬治(Veena George)於17日向議會通報,這波疫情的致死率極高,並且與2024年同期的36例與9死相比,增幅顯著,引發廣泛關注。更令人憂心的是,今年的感染情況不再侷限於過去常見的群聚模式。喬治指出:「與去年不同,今年的個案幾乎都是單一且孤立的,未與特定水源直接相關。」這代表變形蟲可能已廣泛存在於各種自然水域,包括河流、湖泊及其他淡水來源,使得疫情追蹤與防治工作更加困難。在一份官方說明中,喀拉拉邦政府明確指出,病例上升與氣候變遷之間具有高度關聯。當局認為,持續升高的水溫與熱浪,促使更多人參與水上活動,進而提高了接觸被污染水源的機率。雖然由於診斷與治療技術的進步,該邦目前的存活率略為提高至24%,但仍顯不足以應對潛在的擴散威脅。作為因應措施,地方政府已啟動緊急水源管理行動,在水井、水塔及公共沐浴設施中進行大規模加氯作業,並呼籲民眾避免接觸天然水域以降低風險。

婚後才3個月!夏宇童驚診早發性白內障 呼籲定期眼檢保健康
藝人夏宇童與孫協志歷經6年愛情長跑,於今年3月甜蜜步入婚姻。未料婚後才3個月,她便在社群平台透露,日前就醫眼科檢查時,竟被診斷罹患早發性白內障,消息震驚粉絲。她坦言對於36歲便面臨這項眼疾感到難以置信,同時也藉此提醒外界重視眼部健康,定期接受檢查。夏宇童表示,當時她在自家頂樓觀景時,眼前突然出現一條條如變形蟲般的視覺異常,原以為是飛蚊症,隨即前往眼科就診。檢查結果卻顯示,水晶體已有部分混濁,為早發性白內障,雖尚未嚴重到需立即手術,但仍需持續觀察。對於發病原因,夏宇童透露可能與自身曾患有650度高度近視,以及遺傳、老化等因素相關。她坦言震驚之餘,也深刻體認到「眼睛是靈魂之窗」,即便曾接受過近視雷射手術,「看得清楚不代表眼睛沒問題」,因此更應重視日常護眼保健。面對診斷結果,夏宇童雖心情低落,仍樂觀面對。她表示會更加留意生活習慣,包括配戴太陽眼鏡防曬、補充葉黃素等營養保健,也呼籲大眾切勿輕忽眼睛健康,應每年至少安排一次眼部檢查,以早期發現、及時處理,避免視力惡化。夏宇童此番分享,也引發網友廣泛討論與關注,不少人紛紛留言關心並表示會重視眼部檢查。她最後也感性地說:「真的要好好照顧眼睛,不要讓老化來得太快。」36歲的夏宇童坦言對早發性白內障的診斷感到震驚,也藉機呼籲粉絲定期眼檢、重視視力保健。(圖/翻攝自夏宇童IG)

露營時用自來水沖洗鼻腔 德州婦人感染「食腦變形蟲」8天後亡
美國德州1名71歲老婦人因使用自來水沖洗鼻腔,感染了俗稱「食腦變形蟲」(brain-eating amoeba)的「福氏內格里原蟲」(Naegleria fowleri),最終在8天後不幸身亡。綜合《鏡報》、《紐約郵報》的報導,這名未公開姓名的婦人,在去年使用露營地RV供水系統的自來水沖洗鼻腔後,感染了這種單細胞生物。美國疾病管制與預防中心(CDC)實驗室事後也檢測證實,患者腦部及脊髓液中存在福氏內格里原蟲。這種僅有硬幣1/1200大小的微生物,會通過連接鼻腔與大腦的嗅覺神經侵入中樞系統,引發「原發性阿米巴腦膜腦炎」(Primary Amebic Meningoencephalitis,PAM)。初期症狀包括頭痛、嘔吐和噁心,之後會出現頸部僵硬、認知障礙等神經症狀,最終導致腦組織嚴重腫脹壞死。儘管後續有送醫救治,該名女性仍在使用受污染水源4天內出現高燒、意識改變等嚴重神經症狀,並於症狀出現8天後癲癇發作死亡。對此,德州衛生服務部(Texas Department of State Health Services)強調,當地自來水仍可安全飲用,因為這種變形蟲極為罕見,且只能透過鼻腔感染人體。美國每年約發生3起類似案例,1962至2022年間全國共記錄157例,其中德州以39例成為食腦變形蟲病例最多的州,佛州亦有多起報告。報導指出,多數案例發生在民眾夏季於湖泊戲水時,但近年與供水系統相關的案例逐漸引發關注:2020年德州傑克遜湖(Lake Jackson)1名6歲男童疑似因家用水管而感染食腦變形蟲後死亡;2023年佛州夏洛特郡(Charlotte County)1名成人因使用未煮沸的自來水沖洗鼻腔而感染致死。加州大學聖地牙哥分校寄生蟲學家德布納特博士(Dr. Anjan Debnath)解釋:「這種生物感染進程極快,會實質性吞噬腦組織。」從感染到發病約1至9天,患者通常在症狀出現5天內死亡,致死率高達97%。更恐怖的是,由於原發性阿米巴腦膜腦炎的症狀與邊腦膜炎相似,且病例相對罕見,醫師時常會誤診。專家為此也建議:鼻腔沖洗的水應煮沸至少1分鐘,或使用蒸餾水;沐浴、游泳時避免鼻腔進水,可使用鼻夾防護;避免攪動湖底沉積物,因變形蟲易孳生於深水溫暖層;長期未使用的供水系統應先放水流掉數分鐘。CDC指出,雖然飲用含變形蟲的水不會感染,因胃酸可以殺滅微生物,但任何未經處理的淡水都可能存在風險。德布納特博士也特別提醒,在德州、佛州等高溫地區的天然水域活動時應格外謹慎,而在海水裡游泳則相對安全。
芬蘭科學家首次解析「巨型病毒」直徑約200奈米 發現更多未知病毒
芬蘭科學家首次成功分離出一種全新的巨型病毒,並將其命名為「於韋斯屈萊病毒」(Jyvaskylavirus),該項重大發現顛覆人們對巨型病毒地理分佈的既有認知,也為病毒在生態系統中的作用提供了嶄新視角。根據外媒報導,研究由於韋斯屈萊大學奈米科學中心主導,研究團隊在分析環境樣本並將其與卡氏棘阿米巴變形蟲進行培養時,首次發現了這種病毒。於韋斯屈萊病毒的顆粒直徑約為200奈米,體積是流感病毒或新冠病毒的兩倍,大小與某些細菌相當。這項研究不僅證實巨型病毒在芬蘭等北方地區也普遍存在,還發現該病毒與過去於法國發現的馬賽病毒存在親緣關係。研究團隊透過國際合作,成功解析了於韋斯屈萊病毒的基因組與結構,同時在其他環境樣本中也發現了更多未知的巨型病毒。於韋斯屈萊大學教授洛塔裡納桑德伯格(Lotta-Riina Sundberg)表示,「這項發現顯示,巨型病毒在土壤與水域等自然環境中比我們先前認為的更加常見,甚至在寒冷的北方地區也有廣泛分布」。巨型病毒是一類新興病毒,其大小可媲美細菌,通常感染變形蟲與其他微生物。雖然大多數自然病毒對人類無害,但它們在調節微生物族群與維持生態系統平衡方面扮演關鍵角色。桑德伯格指出,「這項發現將有助於我們進一步理解微生物之間的互動,以及病毒在自然界中如何影響整體生物族群的調節機制。」該研究成果已刊登於科學期刊《eLife》系列,為探索巨型病毒的起源、功能與生態意義邁出重要一步。

陸盛行飼養「黏菌」當寵物 博主吐實情:1珠養超過7年
養寵物在現代相當盛行,中國興起養「黏菌」的風氣,因為無毒無害,在歐美和日本也流行,引發討論話題。據《九派新聞》報導,菌物科普博主「曳尾菌」周晴烽解釋,黏菌既不是真菌也不是細菌,而是一種真核生物域變形蟲總群黏菌綱的生物,無毒也無害,平時都躲在陰暗潮濕的地方,只有繁殖階段才會出現在有亮光和略乾燥的地方。繁殖階段黏菌即將變成子實體,也就是母體即將死亡,變成很多孢子。周晴烽介紹,營養階段的黏菌叫作原質團,有點像網路狀的黏液,生長在陰暗潮濕的地方,如倒木的背面、地磚的縫隙、腐殖質層,它們不斷分裂成樹枝狀到處爬行,通過吞噬食物顆粒來獲得營養,這樣到處爬行找東西吃的樣子很像動物。黏菌的壽命很長。(圖/翻攝自九派新聞)黏菌到了繁殖階段,會爬向略乾燥、有陽光的地方,並停止進食,整片原質團集體變身,長出一根根像蘑菇或一團團像粉末的子實體,散播孢子。她在浙江清涼峰採集到第一種愛吃燕麥的黏菌,帶回家飼養後長出很多,截至目前已經飼養7年多,還沒看到壽命的極限,也沒看到任何菌種退化的跡象。觀察發現,一開始購買黏菌的買家,以大學生和2、30歲的年輕人居多,其中有不少玩藝術的買來做裝置藝術,後來小學生數量也越來越多。周晴烽分析,現代大家生活比較安穩,年輕人和小孩喜歡這類新奇的玩意,「我剛玩的時候,黏菌在歐美和日本已經有一定受眾了,但在國內黏菌愛好者幾乎是零」,並且有把握這2年內飼養黏菌的人,已經超過歐美和日本。

全球暖化加劇北極永凍層「上古病毒」問世 專家:擔憂引爆大流行
目前有科學家提出警告,如果沒法阻止全球暖化的腳步加快,在北極永凍層中暗藏的上古病毒「瑪土撒拉微生物菌株」(Methuselah microbes,外號殭屍病毒)有可能會因為溶解的關係而被釋放出來。除此之外,其實在永凍土深層,恐怕還有100萬年前的病毒。根據《衛報》報導指出,法國艾克斯馬賽大學遺傳學家克拉維里(Jean-Michel Claverie)表示,目前全球對於大流行的威脅分析,主要是從南方地區往北方傳播的疾病上研究,但相對的,對那些遠北地區出現、恐向南方傳遞的病毒關注較少。克拉維里認為,這是一種疏忽,因為在北方的永凍層中,其實也有可能出現引發新疾病爆發的病毒。溫室效應造成全球暖化,影響深遠。(圖/達志/美聯社)鹿特丹伊拉斯姆斯醫學中心的病毒學家庫普曼斯(Marion Koopmans)也支持克拉維里的論點,他表示,我們無法知道北極永凍層中到底隱藏了那些古老的病毒,但當中無法排除有的病毒恐引發全球蔓延,比如像是最古老型態的小兒麻痺症,這是我們身為病毒學家必須要能夠假設的事情。永凍層若溶解,許多科學家擔心其中的冰封千萬年的病毒會隨之被釋放造成災難。(圖/達志/美聯社)報導中也提到,克拉維里曾於2014年領導團隊,將西伯利亞的樣本中分離出活病毒,這項實驗足以證明這些病毒即便被掩埋在永凍土中數千萬年,但還是具有感染能力。而在2023年他們進一步的在西伯利亞七個地點取得不同樣本的病毒株,當這些病毒株放入實驗室後,還是可以感染培養細胞,其中一個病毒的樣本年份甚至長達4.85萬年之久。北極圈許多生物已經深受全球暖化影響,家園遭到破壞。(圖/達志/美聯社)克拉維里表示,目前研究團隊分離出來的病毒只能感染變形蟲,對人類沒有風險。但這並不意味著其他目前被凍結在永凍土中的病毒無法引發人類疾病。例如,目前已經識別出天花病毒和皰疹病毒的基因組痕跡,這些都是眾所周知的病毒。報導中也指出,這些被科學家所分析出來的微生物、病毒,均統稱為「瑪土撒拉微生物菌株」(Methuselah microbes,殭屍病毒),但科學家也認為,在永凍層底下,有可能會出現百萬年前的病毒,這種病毒一定遠比人類等所有物種還要古老。克拉維里表示,我們的免疫系統過去從未與這種微生物接觸過,是否有抗體足夠對付也是會讓人擔憂。暖化後的北極永凍土解凍,除了造成交通上障礙,更可能讓原本被冰封的病毒重現。也因為這個原因,克拉維里目前正與北極地區的一個國際教育網絡北極大學(UArctic)建立合作,雙方計畫要建立起一個監視網路、隔離設施,並且從中提供專業的醫療資源與知識,以便早期發現特殊病例,同時也計畫在當地就遏止這種上古病毒的感染。

10歲女童泳池嗆水感染「食腦變形蟲」3周逝世 死亡率高達95%
哥倫比亞一名10歲女孩於度假期間至泳池戲水,沒想到在2天過後,她開始發燒、耳朵疼痛,並於2周後全身異常抽搐,緊急送醫卻回天乏術。經過診斷後,才發現她感染了「福氏內格里蟲」(Naegleria fowleri,俗稱食腦變形蟲)。根據英國《鏡報》(The Mirror)的報導,夢想成為體操運動員的史蒂芬妮亞(Stefanía Villamizar González)在6月與家人們一同至聖瑪爾塔度假,而她於泳池不小心嗆到水後,在2天後更開始有了生病症狀,當時去看了醫生,僅被診斷出疑似是耳朵感染,旅途結束後返家,疼痛情形也已減輕許多。沒想到的是,僅僅兩周過後,史蒂芬妮亞的身體變得時常抽搐,更難以下床。後來,即使家人趕緊將史蒂芬妮亞送往醫院治療,卻還是不幸逝世,經過深入調查後才確定,其死因是由「福氏內格里蟲」引起的腦炎,而這種生物會攻擊生命體的中樞神經系統,死亡機率高達95%。另外,原先涉事的酒店則承諾會加強泳池安全標準,以避免憾事再度發生。報導指出,「福氏內格里蟲」通常生活在土壤和溫暖的淡水湖泊、河流、池塘、溫泉中,也可能出現於沒有適當維護的水池裡,據美國疾病管制與預防中心(CDC)稱,當含有這種細菌的水通過鼻子進入人體時,就會感染人類,並開始食用人類的腦部組織。受到感染的患者,其症狀約在5天後出現,包括嚴重頭痛、發燒、噁心嘔吐等,並快速引起頸部僵硬、癲癇發作、幻覺甚至昏迷。雖然感染的病例很少見,卻是相當致命,存活率僅有3%而已。對此,當地衛生官員提醒,若在溫暖的淡水中游泳時,應該避免運用鼻子吸吐,或是直接使用鼻夾、將頭部保持在水面上,以降低感染的風險。

她游泳後眼睛不適「10周後竟失明」 二度就醫得知:角膜遭食肉菌啃食
英國一名38歲女子葛里芬(Shereen-FayGriffin)在當地運動中心游泳沐浴,2天後左眼居然又癢又痛,雖然她有去看醫生但眼晴情況依舊嚴重,當她再次就醫時發現,左眼被食肉菌感染導致眼睛失明。根據《每日郵報》報導,這起事件發生在肯特郡雷福德(Crayford),葛里芬去年11月9日早上醒來,突然發現左眼失明,她已經飽受眼睛劇痛的情況好一段時間,她懷疑是8月19日在當地運動中心游泳有關,「那天我有去游泳,還用了那裡的淋浴間,早晚都是在家用自然水洗臉」。葛里芬表示,當她再次就醫後發現,原來左眼被阿米巴原蟲感染,罹患棘阿米巴角膜炎(AcanthamoebaKeratitis),由於醫生未在第一時間發現,給予她錯誤的治療才會造成眼睛惡化。根據報導,這種微生物其實常存在家用水或泳池、熱水池中,一般來說不會對人體造成傷害,但若是侵蝕到角膜,就會對眼睛造成嚴重的疾病。葛里芬在另外一位醫生的診治下找到真正病因,「他們讓我接受錯誤的治療長達10周,我一直在吃類固醇,醫生告訴我說,這種罕見傳染病對於治療有很強的抵抗力,因為我一直在吃類固醇,讓變形蟲的抵抗力又變得更強」。葛里芬的左眼視力目前仍未恢復,她未來打算接受角膜手術,但醫生表示,就算進行手術,也不保證視力可以恢復。38歲女子葛里芬在當地運動中心游泳沐浴眼睛竟不適, 二度就醫才發現左眼遭食肉菌感染,導致一隻眼睛失明。(圖/翻攝自推特)

「食腦變形蟲」發生率激增 美國今年已造成4死
美國德州傳出一名游泳選手在湖中游泳後,竟然感染「食腦變形蟲」引發腦膜炎過世,而這已是今年美國第4人死於變行蟲,先前台灣也曾一名30多歲的女子,日前到一家新北市的親水設施游泳後,感染了「食腦變形蟲」,甚至七天後就過世,消息震驚社會,而美國也發現這樣的狀況比例升高。游泳選手在湖中游泳後,就因變形蟲感染腦膜炎過世。(示意圖/翻攝自pixabay)德州公共衛生局發出聲明,指出特拉維斯郡一名游泳選手在8月份於約翰遜湖游泳後,就感染了「食腦變形蟲」,引發阿米巴腦膜炎感染的症狀,首先是出現嚴重頭痛然後發燒、噁心和嘔吐,隨後頸部僵硬、癲癇發作和昏迷,並可能導致死亡。公衛局官員指出,這樣的狀況可能跟水質溫度變高有關,因為變形蟲在溫暖的但水中更適合生存,而德州1962年到2022年間,已知的感染者只有39人,美國則是157人,但今年已出現4人染病死亡。公衛局也表示,在溫暖的淡水從事相關活動時,請閉上鼻子、使用鼻夾或將頭保持在水面以上,不要讓水直接進入鼻中;水溫高、水位低的時期,避免在溫暖的淡水中進行與水有關的活動;避免挖掘或攪動水中沉積物;也不要跳入水中、潛水、滑水,任何可以讓水直接進入鼻腔的行為。

食腦變形蟲檢驗出爐「設施用水皆陰性」 老闆無奈:像經歷第4次疫情
疾管署日前公布,有名女性因確診「福氏內格里阿米巴腦膜腦炎」死亡,在發病前,曾2度前往新北市某室內親水設施遊憩。新北市衛生局獲報後,要求業者預防性停業。22日疾管署公布檢驗結果,該場域與設施相關的水體檢驗皆為陰性,判斷陽性水體應來自自然環境。對此,泳池老闆無奈表示,就好像經歷第4次疫情一樣,身心非常疲憊。事件發生後,新北市衛生局於9日接獲通知,並立即與中央前往該場所採檢環境,10日下午再度同中央及專家對該設施的泳池進出排水口採檢,隨後由中央帶回檢驗。疾管署22日則公佈水質檢驗結果,除了1件地下室積水的檢驗結果為陽性外,該場域與親水設施相關的水體皆為陰性,目前經初步調查,判斷陽性水體的來源,應為自然環境,而非設施的用水,未與親水設施用水交流,民眾並無接觸風險。據《ETtoday新聞雲》報導,該設施老闆曾於10日受訪時,情緒激動的表示,好不容易才從疫情撐過來,現在又出現這種事情,不知道該如何面對。如今對於衛生局的檢驗結果,顯示該場域與設施相關的水體檢驗皆為陰性,只有1件為陽性。對此,老闆則私下表示,就好像經歷第4次疫情一樣,身心非常疲憊,他也透露,期間內場館共清潔4次,消毒公司清潔3次,目前正等待最後的清潔作業完成,會請衛生局稽查,確認安全後才可重新營業。老闆也坦言,自己的家人都在泳池玩,所以他在清潔方面,必定會用盡心力,但他也不想撇清相關責任,畢竟有人因為來他的場館後不幸往生,他也曾到死者靈位致意,表達自己的最大的誠意。

北部女染「食腦變形蟲」身亡 檢驗結果1處陽性…水質來源曝
北部一名30多歲女性日前到室內親水設施玩水,結果感染俗稱「食腦變形蟲」的「福氏內格里阿米巴原蟲」,7月26日出現症狀,8月1日就死亡。衛生單位針對設施水質與環境進行檢測,疾管署今(22日)公布水質檢驗結果,目前不合格的場域正進行環境動線改善,若複查及檢驗合格就可以復業。新北市衛生局在8月9日及8月10日會同中央及專家前往室內親水設施場域進行環境採檢,檢驗結果今天出爐,親水設施相關的水體結果皆為陰性,僅1件地下室積水的檢驗結果為陽性,初步調查來源為自然環境,而非親水設施用水,沒有和親水設施用水交流,因此民眾無接觸風險。新北市衛生局進行環境檢驗。(圖/新北市政府衛生局)據悉,業者自8月9日預防性停業至今,依專家現場檢驗設施整體狀況建議,正進行環境動線改善,等待複查及水質複驗合格後,就可以重新營業。此外,衛生局也依「營業場所傳染病防治衛生管理注意事項」,定期對轄內106家泳池業進行水質檢測,8月份檢驗結果除了10家沒營業,其他96家的酸鹼值全數合格,3家自由有效餘氯不合格,經現場輔導後已複檢合格。新北市衛生局疾管科科長王美華呼籲,民眾在戲水或泡溫泉等活動時,應避免水進入鼻腔、將頭部浸泡於水中,在自然水域戲水時,也應避免攪動底部池水或淤泥,相關業者也要落實執行營業衛生管理事項,包括水池衛生管理、餘氯量符合標準等,並完備相關自主衛生管理措施。

「食腦變形蟲」14件水質檢體呈陰性 專家判:問題恐不在水質
台北市一名30多歲的女子,日前到一家新北市的親水設施游泳後,感染了「食腦變形蟲」的「福氏內格里阿米巴原蟲」,7日後就因腦膜炎過世,消息震驚社會,相關單位也展開相驗,疾管署也送驗了56件檢體,今日公布14件已完成皆為陰性,如今有感染科醫師認為,如果當天那麼多人都在同一個水域戲水,卻只有她一人有狀況,認為問題可能在人而非水質。如今56件檢體,已有14件出爐,皆為陰性。(圖/疾管署提供)由於30多歲女性在去游泳池後,感染了「食腦變形蟲」,並在短時間內因腦膜炎死亡,疾管署與相關單位也對該處水質進行不同的檢驗,今(15)日公佈14件針對入水口、出水口、泳池壁共14件拭子檢體的檢驗結果,顯示均為「陰性」。對於水質問題,感染科醫師與內科醫師也都發表看法,台大醫院內科部主治醫師、微生物專家盛望徽就認為,很有可能其他檢體也「驗不到」細菌,原因為微生物的量相當稀少,另外是因為大部分游泳池都有添加氯,有加氯的泳池通常就難以存在。而感染科醫師中華民國防疫學會,理事長王任賢則指出,「食腦變形蟲」即便使用「氯」來消毒,也有可能存活下來,但當天很多人都在同一個水域,卻只有當事個案發病,認為可能就是「人」的問題。台灣感染症醫學會名譽理事長黃立民則表示,食腦變形蟲一開始是在跳水運動員身上發現,可能因為跳水的高度衝擊,食腦變形蟲從鼻腔帶入腦部,從耳朵或眼睛進入機率相當低,因此一般民眾可以盡量避免跳水,頭部也別浸泡到水。

北部女染「食腦變形蟲」亡!親水設施採檢出爐 進出水口等3處陰性
疾病管制署9日表示,國內發生俗稱「食腦變形蟲」的「福氏內格里阿米巴原蟲(Naegleriafowleri)」感染個案,為北部30多歲女性,發病前曾前往新北市某室內親水設施,7月26日出現症狀,於1日死亡。衛生單位針對設施水質與環境進行檢測。疾管署今(15日)公布初步檢驗結果,10處檢體有3處為陰性,其餘還在檢驗中。疾管署表示,個案為北部一名30多歲女性,近期無國外旅遊史,發病前曾前往室內親水設施遊憩,今年7月26日出現頭痛及肩頸僵硬症狀,後續出現發燒、畏寒、頭痛、頸部疼痛抽搐就醫,後續病程進展快速,於1日死亡;診療醫院通報不明原因腦炎,採集檢體送疾管署實驗室檢驗,確認為福氏內格里阿米巴原蟲感染所導致的腦膜腦炎。台北市衛生局日前表示,目前已完成個案疫調,確認對方近期除了7月21日前往新北某室內親水設施遊憩外,沒有去過其他地方玩水。另一方面,新北市衛生局已要求該業者預防性暫停營業,並會同疾管署進行環境採檢以釐清感染源,預計近期會有初步結果,檢測報告則估1到3週後出爐。疾管署今日公布初步檢驗結果,採集的10處檢體中,有3處結果已出爐,包括進出水口等處,檢測結果為陰性,剩餘7處檢體還在檢驗中。另一方面,疾管署專家會議也提出強化防治建議,其中一項要求針對7月21日至8月9日間曾到該場域遊憩的民眾,以最後暴露日為準,進行健康關懷14天。疾管署提醒,福氏內格里阿米巴原蟲好發於夏季,籲請民眾於戲水或泡溫泉等活動時,應避免水進入鼻腔,或避免將頭部浸泡於水中,於自然水域戲水時,亦應避免攪動底部池水或淤泥;戲水或泡溫泉後出現發燒、頭痛、噁心或嘔吐等症狀,應儘速就醫,並告知醫護人員相關接觸史。相關資訊可至疾管署全球資訊網(https ://www.cdc.gov.tw),或撥打免付費防疫專線1922(或0800-001922)洽詢。

北部女染「食腦變形蟲」發病7天亡 專家提醒「關鍵」在這裡!
台北市一名30多歲女性感染阿米巴原蟲腦膜腦炎死亡,北市衛生局13日公布疫調結果,死者發病前2周僅到新北市某室內親水設施玩水,沒去過其他水域。新北市監控曾去過該場所的630位民眾,經過2天聯繫,還有45人未找到,昨已發送簡訊通知,目前尚未接獲出現相關疑似症狀通報。中華民國防疫學會理事長王任賢則提醒,政府一出事就啟動水質稽查,是搞錯方向了。北市衛生局疾病管制科長張惠美昨表示,染病死亡的女性住在台北市,根據疫調結果,發病前14天僅在7月21日前往新北市某親水設施玩水,並沒去過其他水域,其家人沒有同行,目前無症狀。張惠美指出,該親水設施採預約制,新北市衛生局已取得名單,並監控曾去過該場所的消費者、工作人員健康狀況,感染的具體原因有待疾管署釐清及判斷。新北市衛生局監控去過該親水設施的630位民眾,昨發簡訊通知未取得聯繫的45人,目前尚未接獲有疑似症狀通報,市府須待環境與水質檢驗報告出爐後,才會決定是否讓該室內親水設施業者復業。感染科權威王任賢指出,食腦變形蟲自由生存在水中,不見得可被氯消滅,該案關鍵出在「人」非水質,除了該位不幸的年輕女性,同一場域當日應該有很多人,為何只有她發病?關鍵就是人的問題。王任賢說,福氏內格里阿米巴原蟲被稱為食腦變形蟲,是跟感染方式有關,它會在水中從眼、鼻進入腦部,引發腦膜炎;從國外文獻可知,該病症一開始是在跳水運動員身上發現,顯示跳水的高度衝擊,會把食腦變形蟲從鼻帶入腦部,呼籲民眾戲水少做跳水動作,到溫泉池沖水柱時也不要沖臉鼻。王任賢強調,食腦變形蟲侵入人體一旦併發腦炎死亡率99%,政府這種一出事就啟動水質稽查是搞錯方向,應好好宣導讓民眾了解如何預防。他也特別呼籲,食腦變形蟲進入人腦還有一個途徑是眼睛,戴隱形眼鏡或眼部有眼疾、創傷者,戲水一定要戴蛙鏡保護。

北部女染「食腦變形蟲」發病7天亡 疫調結果出爐…去過新北這親水設施
疾病管制署9日表示,國內發生俗稱「食腦變形蟲」的「福氏內格里阿米巴原蟲(Naegleriafowleri)」感染個案,為北部30多歲女性,發病前曾前往室內親水設施遊憩,7月26日出現頭痛及肩頸僵硬症狀,於1日死亡。對此,北市衛生局今(13日)表示,已完成個案疫調,確認除了新北某室內親水設施遊憩外,個案沒去過其他地方戲水。疾管署表示,個案為北部一名30多歲女性,近期無國外旅遊史,發病前曾前往室內親水設施遊憩,今年7月26日出現頭痛及肩頸僵硬症狀,後續出現發燒、畏寒、頭痛、頸部疼痛抽搐就醫,後續病程進展快速,於1日死亡;診療醫院通報不明原因腦炎,採集檢體送疾管署實驗室檢驗,確認為福氏內格里阿米巴原蟲感染所導致的腦膜腦炎。台北市衛生局今天接受訪問表示,目前已完成個案疫調,確認她近期除了7月21日前往新北某室內親水設施遊憩外,沒有去過其他地方玩水。另一方面,新北市衛生局已要求該業者預防性暫停營業,並會同疾管署進行環境採檢以釐清感染源,預計近期會有初步結果,檢測報告則估1到3週後出爐。疾管署監測資料顯示,澳洲於1965年發現首例人類感染福氏內格里阿米巴原蟲病例,國際間近5年於巴基斯坦(信德省)及美國持續有零星個案;其中巴基斯坦每年約10例;而美國每年約5例,以7至8月為多,自1962年至2022年累計157例;去年泰國及今年印度亦曾有零星感染案例;我國曾於2011年確診1例因接觸溫泉水感染福氏內格里阿米巴腦膜腦炎死亡病例。疾管署指出,福氏內格里阿米巴原蟲為淡水湖泊、河流中自然生存的單細胞寄生蟲,喜好溫暖環境,能生存於46℃的溫熱環境中,在更高的溫度下也可短暫存活。溫暖的淡水(如湖泊及河川)、溫泉水、工廠排出的溫水、含氯量不足的游泳池、熱水器及土壤中都可發現其蹤跡。人類可能在自然水域活動時,將病原體吸入鼻腔,並沿著嗅覺神經進入腦部而發病,但喝下遭病原體污染的水則不會被感染,也不會透過人與人接觸傳播,人類病例罕見。疾管署說明,該疾病潛伏期約1至7天,發病後病程進展快速,初期症狀為頭痛、發燒、噁心、嘔吐,之後出現頸部僵硬、抽搐、意識變化、譫妄、昏迷等腦炎症狀,發病後死亡率約99%。疾管署強調,地方衛生單位已對該室內親水設施進行環境採檢以釐清感染源,並依傳染病防治法第21條,請業者預防性停業及進行環境清消。疾管署提醒,福氏內格里阿米巴原蟲好發於夏季,籲請民眾於戲水或泡溫泉等活動時,應避免水進入鼻腔,或避免將頭部浸泡於水中,於自然水域戲水時,亦應避免攪動底部池水或淤泥;戲水或泡溫泉後出現發燒、頭痛、噁心或嘔吐等症狀,應儘速就醫,並告知醫護人員相關接觸史。相關資訊可至疾管署全球資訊網(https ://www.cdc.gov.tw),或撥打免付費防疫專線1922(或0800-001922)洽詢。

網傳泳池食腦變形蟲案642人有危險? 專家:多數7日內就會有症狀
北部一名30多歲女子日前感染俗稱「食腦變形蟲」的福氏內格里阿米巴腦膜腦炎,從發病到死亡只有短短7天。而在發病前,她曾2度前往新北市某室內親水設施遊憩。新北市衛生局也為此匡列7月21日至8月9日曾出沒此地的顧客、員工,人數共計642人。網路甚至一度傳出這642人都有感染的風險,而台北醫學大學醫學系寄生蟲學科主任范家堃表示,如果水質遭到大範圍汙染,確診人數不會只有1個,而且就算真的感染,7日內也會有症狀出現,曾出沒相關場所的民眾不用過度緊張。整起事件爆發後,疾管署於10日表示,已請業者提供7月21日至8月9日曾至該場域遊憩之民眾名冊,由地方政府進行追蹤關懷,時間直至最後1次暴露日的14天後。同時也請業者於8月9日預防性停業及進行環境清消,業者於完成環境澈底清消,且經地方主管機關同意後始可復業。業者也同步發出聲明,表示會停業一周,進行全館清潔與消毒作業,待衛生局檢測完成合格後,才會開放營業。也由於新北市衛生局最後匡列人數共計642人,更表示要逐一監測健康狀況,此舉引發不少民眾擔憂,網路甚至有傳聞傳出「這642人都有感染風險」等語。根據媒體報導指出,台北醫學大學醫學系寄生蟲學科主任范家堃表示,雖然福氏內格里阿米巴原蟲隨處可見,但是發生在室內泳池的感染個案真的是十分罕見。范家堃解釋,如果水質內真的遭遇大規模的福氏內格里阿米巴原蟲汙染,那麼到現在感染案例人數不會只有1人。而且患者如果遭到感染,大部分在7天內會出現腦膜炎的症狀。而從9日至今已經超過一周,他認為目前衛生局所匡列的642人就是靜待兩個潛伏期結束後就沒事情了。先前疾管署也曾呼籲,福氏內格里阿米巴原蟲好發於夏季,請民眾於戲水或泡溫泉等活動時,應避免水進入鼻腔,或避免將頭部浸泡於水中,於自然水域戲水時,亦應避免攪動底部池水或淤泥;戲水或泡溫泉後出現發燒、頭痛、噁心或嘔吐等症狀,應儘速就醫,並告知醫護人員相關接觸史。

北部女染食腦變形蟲亡 親水設施預行性停業!發聲明:員工、家屬都在館內游泳
北部一名30多歲女子日前感染俗稱「食腦變形蟲」的福氏內格里阿米巴腦膜腦炎,從發病到死亡只有短短7天。而在發病前,她曾2度前往新北市某室內親水設施遊憩。對此業者發出聲明表示,本場館已進行預行性停業,待衛生局檢測完成合格後,才會開放營業;業者強調,本場館全體員工、家屬也都每日在場館內活動、游泳,請大眾安心。疾管署10日表示,因應國內發生福氏內格里阿米巴感染個案,已請業者提供7月21日至8月9日曾至該場域遊憩之民眾名冊,由地方政府進行追蹤關懷至最後1次暴露日後14天;同時該親水設施業者已於8月9日預防性停業及進行環境清消,業者於完成環境澈底清消,且經地方主管機關同意後始可復業。疾管署指出,福氏內格里阿米巴原蟲為淡水湖泊、河流中自然生存的單細胞寄生蟲,雖常見於自然水體,但造成人類感染機率極低,地方衛生單位已對該室內親水設施進行環境採檢以釐清感染源,分別由地方衛生單位及疾管署進行檢測,預計約3-4日可有初步檢驗結果。疾管署呼籲,福氏內格里阿米巴原蟲好發於夏季,請民眾於戲水或泡溫泉等活動時,應避免水進入鼻腔,或避免將頭部浸泡於水中,於自然水域戲水時,亦應避免攪動底部池水或淤泥;戲水或泡溫泉後出現發燒、頭痛、噁心或嘔吐等症狀,應儘速就醫,並告知醫護人員相關接觸史。至於業者則發出聲明表示,本場館已進行預行性停業,約為期一週,進行全館清潔與消毒作業,待衛生局檢測完成合格後,才會開放營業。業者強調,本場館有做每日的泳池消毒工作,也有泳池過濾系統,本場館全體員工、家屬也都每日在場館內活動、游泳,請大眾安心。

北市抽查12行政區游泳池環境衛生 竟高達8成不及格
女子感染「食腦變形蟲」病發身亡,引發各界關心親水設施環境、衛生。台北市議員王欣儀揭露,北市府抽查全市游泳池,竟有高達8成不及格,有地磚破損、防滑條脫落,甚至滑水道長青苔,她擔心只是冰山一角;桃園市5至7月抽驗泳池、三溫暖及溫泉108家次,有39件不合格。一名30多歲女子染福氏內格里阿米巴腦膜腦炎7日病發身亡,經查她曾去過新北市某室內親水設施。新北市衛生局昨表示,環境與水質檢體初步檢驗結果最快1周出爐,前天已逐一致電關懷追蹤7月21日至8月9日曾至該場域遊憩630位民眾,提醒為期2周自主健康監測,有68位未接聽,餘562位目前無疑似症狀。新北市衛生局說,依衛福部「營業衛生傳染病防治管理規則」,泳池池水餘氯濃度建議保持每公升1到3毫克,現場檢測大池每公升0.86毫克、小池0.06毫克,皆未達標準,前天已輔導業者改善並加強清消,待水質檢驗出爐,若檢出阿米巴原蟲,將依《消保法》開罰6到150萬元。王欣儀昨揭露,北市府抽查12行政區游泳池,竟然高達8成不及格,有的地磚破損、地板未置放防滑設施、階梯防滑條脫落,還有兒童戲水池台階、滑水道長青苔,或滑水道水池破損仍開放使用、未備妥救生繩等。她擔憂抽樣結果恐怕只是「冰山一角」,目前北市教育局、體育局主管的游泳池有153個,若按這次合格率推估,恐怕有超過125個游泳池不及格。市府則回應,會加強檢核與督導力度,對未改善的營運廠商開罰。針對福氏內格里阿米巴腦膜腦炎治療方法,哈佛大學公衛博士李建璋指出,目前美國疾管局(CDC)建議採用藥物組合,包括抗黴菌藥物、紅黴素、利福平、米替福新(miltefosine)和類固醇,但除了米替福新之外,其他傳統藥物的療效僅有1位倖存者,死亡率高達99%;2013年米替福新問世,開始在零星案例中嘗試治療福氏內格里原蟲腦炎,此後出現3名倖存兒童。李建璋認為,台灣的醫療系統或許需要安排一些預算來備用這種藥物,可提供醫生在面對困難疾病時多一項治療選擇。

女染食腦變形蟲亡!衛生局聯繫562位民眾皆無症狀 仍有68人未連繫上
9日疾管署表示,北部一名女性因確診「福氏內格里阿米巴腦膜腦炎」於8月1日死亡,在發病前,曾2度前往新北市某室內親水設施遊憩。9日新北市衛生局接獲通知後,立即與中央前往該場所採檢環境,10日下午再度同中央及專家對該設施的泳池進出排水口採檢,隨後由中央帶回檢驗。11日新北市衛生局指出,10日主管機關已逐一致電關心,曾至該場域的630位民眾,除68位未接聽,餘562位目前均無疑似症狀。新北衛生局表示,10日下午已會同中央及專家,再次前往個案生前曾去的室內親水設施,並針對2座水池的進水口、排水口環境採驗,隨後由中央帶回檢體,估計最快1週,初步檢驗結果會出爐。11日新北市衛生局也指出,10日主管機關已逐一致電關心及追蹤於7月21日至8月9日,至該場域遊憩的630位民眾,同時也提醒民眾要進行為期兩週的自主健康監測,除68位未接聽外,其餘562位目前均無發燒、頭痛、噁心或嘔吐等症狀。未聯繫上的民眾,11日衛生局也將持續電話聯絡。衛生局呼籲相關業者,務必落實水池衛生管理、餘氯量符合標準等,並完備相關自主衛生管理措施,以保障民眾安全健康。衛生局也提醒民眾,於戲水或泡溫泉等活動時,應避免水進入鼻腔,或避免將頭部浸泡於水中,於自然水域戲水時,亦應避免攪動底部池水或淤泥,戲水或泡溫泉後出現發燒、頭痛、噁心或嘔吐等症狀,應儘速就醫。

「食腦變形蟲」致死率9成 醫建議進口藥儲備
北部30多歲女性遭阿米巴原蟲感染導致腦膜腦炎,7天後不幸病逝,為國內史上第2例。流行病學專家指出,阿米巴原蟲俗稱「食腦蟲」,是當今世上致死率最高的微生物,目前文獻僅有5位倖存者。隨著全球暖化,食腦蟲感染在全球發生率有上升的趨勢,早期使用特殊抗菌藥物有助於搶救性命,建議政府可考慮專案進口儲備。對此,疾管署發言人曾淑慧表示,我國病例僅2例,會再評估是否把相關藥物納入專案進口。哈佛大學公衛學院博士、台大醫院急診科醫師李建璋表示,食腦蟲喜歡生活在溫水水域,通常要25℃以上的水,46℃的水溫則是食腦蟲生長最快速的環境。受暖化影響,全球平均溫度不斷上升,有利食腦蟲生存,甚至北方國家如南韓,去年也發生案例。李建璋指出,食腦蟲可能是當今世上致死率最高的微生物,美國文獻上記錄的157位患者,有153位死亡,更可怕的是,免疫功能正常的年輕人也不能倖免。食腦蟲通常是在野溪游泳、野地溫泉戲水時,從鼻腔途徑感染。李建璋提醒,臨床症狀上,食腦蟲導致的腦膜炎和其他細菌腦膜炎無法分辨,所以一定要主動告知野外戲水的暴露史,以利判斷。李建璋說,食腦蟲雖然致死率超高,目前文獻僅有的5位倖存者還是提供寶貴的治療經驗,最重要經驗是早期使用特殊抗菌藥物米替福新miltefosine(Impavido)。米替福新早期用於對抗乳癌,後來發現對於熱帶疾病利什曼原蟲有效,2016年取得美國食品藥物管理局藥證。但李建璋指出,此藥屬於孤兒藥,台灣似乎沒有此藥,如果台灣已經有相關案例,政府可以考慮專案進口儲備。